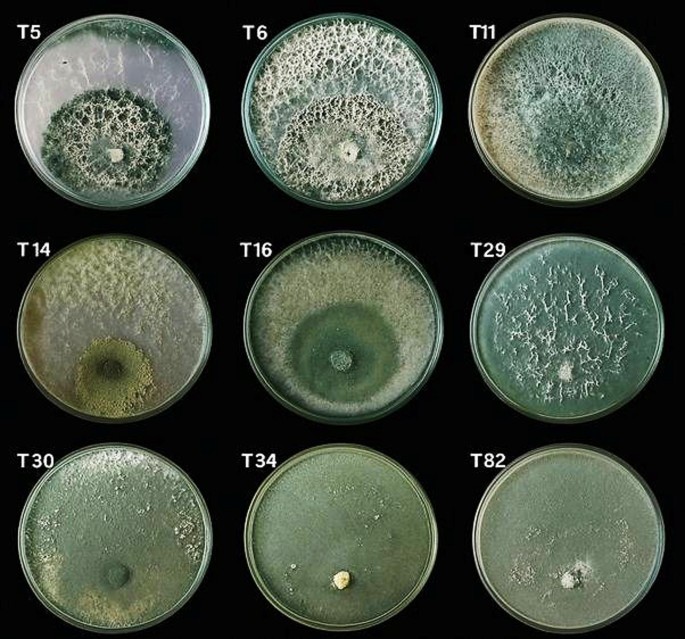
Fig. 8
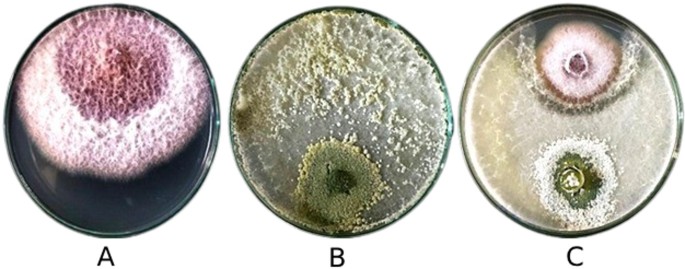
Fig. 9

Abstract
Maize (Zea mays L.) is the world’s third most important cereal crop, valued for its roles in human food, animal feed, industrial products, and biofuels. Its seeds harbor diverse endophytic fungi that can affect seed quality, plant health, and resilience. Given the vertical transmission of seed microbiota, this study investigated the diversity of seed-borne fungal endophytes in Egyptian maize cultivars across 18 governorates and assessed their associations with regional climate. In addition, the study evaluated the antagonistic activity of native Trichoderma isolates as potential biocontrol agents against Fusarium verticillioides, a major seed-borne pathogen threatening maize production. A total of 34 endophytic fungal species from 23 genera were identified. Aspergillus niger, Penicillium spp., A. flavus, and F. verticillioides were the most prevalent, with A. niger occurring in 97.2% of sites and F. verticillioides in 89.6%. Relative abundances were highest for Penicillium spp. (20.08%), A. niger (18.15%), and F. verticillioides (14.93%). Diversity metrics varied regionally, with species richness ranging from 8 to 22 and Shannon diversity indices (H) from 1.02 to 2.46. Canonical correspondence analysis revealed that temperature, solar radiation, and humidity collectively explained 63.6% of fungal community variation. Trichoderma longibrachiatum (T14) demonstrated the strongest antagonistic effect, inhibiting F. verticillioides growth by 74.03% in vitro and exhibiting pronounced mycoparasitic features. This study highlights the dominance of a core group of seed-borne endophytes in Egyptian maize and underscores the significant role of climate in structuring fungal communities. However, as this study was based on single-season, culture-dependent data with limited molecular validation, further multi-seasonal and molecular-based investigations are needed to confirm these patterns and fully characterize the maize seed mycobiome. Notably, T. longibrachiatum demonstrated strong biocontrol potential against F. verticillioides, offering promise as a native, eco-friendly biocontrol agent for maize production systems in semi-arid environments.
Introduction
Maize (Zea mays L.) is the third most important cereal crop globally, following rice and wheat, and plays a critical role in global food security, animal feed systems, feedstock for several industrial products, and a source of biofuels1,2,3. In Egypt, maize is cultivated across nearly 913,000 hectares, with an estimated annual production of 6.9 million tonnes4. This cultivation spans diverse agro-climatic regions, from the Nile Valley to the Delta and Upper Egypt, offering a unique opportunity to investigate how local environmental conditions shape seed-associated fungal communities5.
Despite its global importance, maize remains highly vulnerable to a wide range of fungal pathogens, many of which are seed-borne and capable of reducing grain quality, yield, and viability. Among these, F. verticillioides stands out for its destructive capacity, it causes seed rot, impairs germination, and induces ear and stalk infections that result in fumonisin mycotoxin accumulation, posing serious risks to both human and animal health6. Recent metabolomic and field studies have revealed that maize kernels infected by this fungus can accumulate high levels of FB1 and FB2 toxins while remaining symptom-free, making contamination difficult to detect7. Furthermore, F. verticillioides often dominates as the major toxigenic species in maize-growing regions, with its persistence in seeds and under storage conditions further intensifying the problem8. These factors highlight the urgent need for effective and sustainable management strategies.
Historically, the management of F. verticillioides has relied heavily on chemical fungicides. Systemic formulations such as tebuconazole + trifloxystrobin and prochloraz have been shown to suppress fungal mycelial growth by over 80% under laboratory conditions9. Similarly, the volatile compound 1-octyn-3-ol completely inhibited fungal growth and fumonisin B1 production during grain storage10. However, despite their short-term efficacy, the extensive use of synthetic fungicides raises environmental and health concerns, including residual toxicity, soil contamination, and the emergence of resistant strains11. These drawbacks have prompted a global shift toward eco-friendly and biologically based alternatives12.
In this context, biological control agents have gained increasing attention as environmentally safe alternatives. Among these, endophytic fungi are particularly promising due to their ability to colonize internal plant tissues without causing harm, while simultaneously enhancing plant growth, stress tolerance, and disease resistance13,14,15. The dual role of endophytes in promoting plant health and enhancing host defense makes them valuable components of sustainable agricultural strategies16,17,18,19,20,21.
Previous studies have provided compelling evidence for the biocontrol potential of maize-associated endophytic fungi against Fusarium pathogens. For example, Li et al.8 reported that a maize-derived endophyte exhibited dual antagonism against F. verticillioides, effectively inhibiting its growth and reducing fumonisin accumulation. Likewise, Mirsam et al.22 demonstrated that indigenous maize endophytes suppressed the pathogen by over 50% in vitro and improved seed germination. Together, these findings underscore that maize-associated endophytes not only suppress diseases but also enhance plant vigor and resilience, offering an ecologically compatible approach for integrated pathogen management.
Building on these promising insights, it remains essential to further understand how seed-borne endophytic fungi adapt and function under different environmental conditions, particularly within arid and semi-arid ecosystems.
Although previous research has highlighted the potential of endophytic fungi as effective biocontrol agents, a comprehensive understanding of their diversity and ecological adaptation in arid regions remains limited. Most existing research has focused on endophytic fungi associated with maize roots and leaves, offering valuable insights into their roles in plant growth promotion and disease resistance23,24,25,26. However, much less is known about seed-borne endophytes and their adaptive responses across contrasting environmental conditions.
The structure and composition of endophytic fungal communities are influenced by multiple environmental factors, including temperature, relative humidity, precipitation, and solar radiation27,28,29,30,31,32. These variables not only affect fungal abundance and distribution but also drive regional variations in community diversity and functional traits33,34,35,36,37. Among them, precipitation plays a particularly important dual role, facilitating the dispersal of fungal propagules while simultaneously shaping community composition through microclimatic effects38,39.
Within this ecological framework, species belonging to the genus Trichoderma have gained growing attention for their ability to suppress plant pathogens through multiple mechanisms, including competition, antibiosis, and mycoparasitism. Several Trichoderma species have been recognized as effective biocontrol agents against Fusarium pathogens40,41. However, most previous work has focused on soil-borne or foliar applications, while the potential of seed-borne Trichoderma isolates, particularly native strains adapted to local agroecological conditions, remains largely unexplored.
Therefore, this study was designed to address these knowledge gaps by: (i) characterizing the diversity and distribution of seed-borne endophytic fungi in maize seeds collected from 18 agroecologically diverse Egyptian governorates; (ii) analyzing the influence of regional climatic variables on the structure of these fungal communities; and (iii) evaluating the antagonistic potential of selected native Trichoderma isolates, particularly Trichoderma longibrachiatum, as prospective biocontrol agents against F. verticillioides, a key seed-borne pathogen of maize. This integrated approach aims to combine ecological characterization with preliminary biocontrol screening to support future endophyte-based disease management strategies in semi-arid maize production systems.
Results
Morphological characterization of endophytic fungi
Microscopic and cultural examinations revealed pronounced morphological diversity among the isolated endophytic fungi. When cultivated on potato dextrose agar (PDA), the isolates exhibited distinct variations in colony texture, pigmentation, and growth rate. Genera such as Aspergillus and Penicillium typically formed dense, pigmented colonies with abundant sporulation, whereas Fusarium species developed cottony, aerial mycelia with pink to violet pigmentation. Trichoderma isolates were readily distinguished by their rapid radial growth and the progressive -colour transition from white to green as conidia matured.
At the microscopic level, the isolates displayed diagnostic features in conidiophore branching, phialide arrangement, and conidial morphology, consistent with their respective genera. Representative colony and microscopic characteristics are illustrated in Figs. 1 and 2, and key diagnostic traits are summarized in Supplementary Table S1.
Collectively, these morphological observations confirm the distinct taxonomic identity of the isolates and provide a reliable foundation for subsequent analyses of ecological distribution and antagonistic potential.
Habit characters of endophytic seed-borne mycobiomes on maize seeds showing: (a) whitish to purplish-white, cottony and profuse mycelium of Fusarium verticillioides covering the seed (arrow), and fast-growing, light to dark brown mycelium of Chaetomium spp. with submerged, loose brown perithecia covering the entire seed (arrowhead); (b) yellow-green conidial heads of Aspergillus flavus on maize seed (arrowhead); (c) whitish to buff-brown, smooth, cottony mycelium of F. incarnatum (arrow) and black powdery conidial heads of A. niger (arrowhead) covering the seeds; (d) slimy colonies of Aureobasidium pullulans covering the seeds (arrow); and (e,f) yellow-green, fast-spreading aerial mycelium of Trichoderma spp. confined below and around the seeds (arrows). Photographs were taken after 4 days of incubation using the agar plate (AP) method.
Stereoscopic and microscopic micrographs of dominant endophytic fungi isolated from maize seeds showing: (a, ×64; b, ×120) whitish, powdery mycelial growth and conidiophores bearing chains of microconidia and spore heads of Fusarium verticillioides (arrows); (c, ×64) branched conidiophores bearing conidia of F. incarnatum (arrow); (d, ×64) abundant mycelial growth and spore heads of Penicillium spp. (arrowhead); (e, ×120) Aspergillus flavus spore heads (arrowhead, (f, ×64) yellowish-green, fluffy to velvety conidiophores and conidia of Trichoderma spp. covering maize seeds (arrow); (g, ×64) black powdery mycelium and spore heads of A. niger (arrowheads); (h, ×64) dense, dark brown, velvety conidiophores and conidia of Curvularia lunata (arrowhead); (i, ×64) white mycelium bearing conidiophores ending with conidial droplets of Cephalosporium acremonium conidia (arrowhead; (j, ×1000) typical macroconidia and chlamydospores of F. incarnatum; (k, ×1000) micro- and macroconidia of F. verticillioides; and (l, ×1000) smooth-walled, dark conidia and conidiophore of C. lunata.
Occurrence and distribution of maize seed-borne endophytic mycoflora
Building on these morphological characterizations, the seed-borne endophytic mycobiota of maize were subsequently analyzed to determine their occurrence and distribution across Egypt’s major maize-growing governorates during the 2021 cropping season.
A total of 144 maize grains samples were collected from eighteen maize-growing governorates (8 site per governorate). These samples included thirteen hybrids of Egyptian maize cultivars. Among them SC-168, SC-178, SC P3433, TWC-360, and TWC-368 are yellow maize hybrids, while SC-30 K8, SC-30 K9, SC-132, SC-2030, SC-2031, SC-30P74, TWC-321, and TWC-324 represent white maize hybrids.
In total thirty-four endophytic fungal species belonging to twenty-three genera were detected in the maize grains. Colonization percentages were calculated based on the total number of colonies recovered per governorate (Table S2), ranged from 0.0% to 40.8% (Fig. 3), highlighting pronounced differences in fungal abundance among regions and taxa. The colonization rates of seed-borne fungi exhibited marked variation among Governorates and fungal species (Fig. 3). Fusarium spp. displayed the highest observed colonization rate, reaching 40.8% in one Governorate (in Kafr El Sheikh), indicating strong prevalence in certain regions followed by Penicillium spp. reached 32.25% colonization in Giza Governorate. Similarly, A. niger and A. flavus showed high colonization rates in multiple locations, with maximum percentages of 22.88% and 17.6%, respectively. In contrast, less frequent taxa such as Ulocladium spp., Rhizoctonia solani, and Rhizopus spp. had colonization rates below 1% in most Governorates.
The mean colonization percentages across all Governorates (“Egypt Mean”) further emphasized the predominance of Penicillium spp. (8.52%) and A. niger (7.71%), followed by Fusarium spp. (6.34%) and A. flavus (5.85%). The overall pattern highlights a small group of fungi consistently contributing to seed colonization across diverse ecological regions. The heatmap visualization underscores these trends, with warmer colors corresponding to higher colonization rates.
Frequencies per-governorate revealed marked variability in the distribution of endophytic fungi among regions (Fig. 4). In several governorates, notably Luxor and Al-Behera, common taxa such as A. niger and Penicillium spp. were detected in all eight sampled sites, corresponding to a per-governorate frequency of 100%.
Endophytic mycobiome diversity in maize seeds
Analysis of national frequency and relative abundance revealed that a small subset of endophytic fungi was both highly prevalent and dominant in maize seeds across Egypt. A. niger was the most widespread taxon, occurring in 97.22% of all sampled sites and accounting for 18.15% of total colony counts (relative abundance). Penicillium spp. and A. flavus were similarly frequent (93.06% and 92.36%, respectively) and exhibited high relative abundances (20.08% and 13.78%). F. verticillioides was also prominent, detected in 89.58% of sites and contributing 14.93% of relative abundance. In contrast, taxa such as Aureobasidium pullulans and Cladosporium spp. were detected in 62.50% and 66.67% of sites, respectively, yet showed markedly different relative abundances (13.63% and 5.26%) (Fig. 5). These patterns indicate that while certain species were consistently recovered across locations, their proportional representation in the total fungal community varied substantially.
The richness, and Shannon–Wiener diversity index (H) varied substantially among governorates. Richness values among governorates ranged from 8 species in Damietta to 22 species in both Luxor and Al-Behera while Shannon diversity indices spanned from 1.02 (Kafr El-Sheikh) to 2.46 (Al-Behera), reflecting marked differences in community evenness and complexity across regions. Notably, governorates such as Al-Behera, Luxor, and Assiut combined high richness with elevated Shannon indices, indicating diverse and relatively balanced fungal assemblages, whereas areas like Kafr El-Sheikh and Damietta exhibited lower diversity and richness overall.
At the site level, mean richness per governorate ranged from 5.00 ± 2.07 to 12.75 ± 5.06 species, indicating substantial variability among local assemblages while the mean site-level Shannon diversity indices ranged between 1.09 ± 0.6 and 2.1 ± 0.29, further illustrating regional heterogeneity in species evenness and abundance distributions (Fig. 6). Generally, governorates with higher aggregated richness and diversity also exhibited higher mean site-level indices and lower variability, while less diverse regions showed greater inconsistency across sites. The aggregated results for each governorate, comprising the total number of recovered fungal colonies, the observed species richness and Shannon–Wiener diversity index (H), as well as the mean and standard deviation of these diversity indices across site-level samples, are summarized in Supplementary Table 3 (Table S3). This comprehensive table provides an integrated perspective on both fungal colonization intensity and biodiversity metrics, facilitating inter-regional comparisons.
Heatmap showing colonization percentages of endophytic fungi isolated from maize seeds across Egypt’s 18 maize-growing governorates. Each cell represents the mean colonization percentage of a fungal species within a governorate, averaged across all sampling sites. The gradient scale ranges from 0% (blue) to 40.8% (red). Ab. spp. (Absidia spp.), (A) alt. (Alternaria alternata), Arth. spp. (Arthrobotrys spp.), Asp. cla. (Aspergillus clavatus), Asp. fla. (A. flavus), Asp. fum. (A. fumigatus), Asp. gla. (A. glaucus), Asp. nig. (A. niger), Asp. och. (A. ochraceus), Asp. tam. (A. tamarii), Asp. terr. (A. terreus), Auro. pul. (Aureobasidium pullulans), (B) haw. (Bipolaris hawaiiensis), B. may. (B. maydis), B. tet. (B. tetramera), Bot. cin. (Botrytis cinerea), Ceph. acr. (Cephalosporium acremonium), Chaet. spp. (Chaetomium spp.), Cl. spp. (Cladosporium spp.), Coll. spp. (Colletotrichum spp.), Cu. lun. (Curvularia lunata), Epi. pur. (Epicoccum purpurascens), F. inc. (Fusarium incarnatum), Fus. spp. (Fusarium spp.), F. ver. (F. verticillioides), Muc. spp. (Mucor spp.), Nig. spp. (Nigrospora spp.), Pen. spp. (Penicillium spp.), Phom. sp. (Phoma sp.), R. so. (Rhizoctonia solani), R. sto. (Rhizopus stolonifer), St. spp. (Stemphylium spp.), Trichod. spp. (Trichoderma spp.), and Ulo. spp. (Ulocladium spp.). The final row “Egypt” in the table represents the mean frequency (%) of each fungal species across all surveyed governorates, providing an overall profile of seed-borne fungal prevalence. This summary row was excluded from comparative analyses and visualization.
Heatmap showing the per-governorate frequencies of 34 endophytic fungal species associated with maize seeds collected from Egypt’s 18 maize-growing governorates. The frequency gradient ranges from 0% (blue) to 100% (red), as indicated on the scale bar. Ab. spp. (Absidia spp.), (A) alt. (Alternaria alternata), Arth. spp. (Arthrobotrys spp.), Asp. cla. (Aspergillus clavatus), Asp. fla. (A. flavus), Asp. fum. (A. fumigatus), Asp. gla. (A. glaucus), Asp. nig. (A. niger), Asp. och. (A. ochraceus), Asp. tam. (A. tamarii), Asp. terr. (A. terreus), Auro. pul. (Aureobasidium pullulans), (B) haw. (Bipolaris hawaiiensis), B. may. (B. maydis), B. tet. (B. tetramera), Bot. cin. (Botrytis cinerea), Ceph. acr. (Cephalosporium acremonium), Chaet. spp. (Chaetomium spp.), Cl. spp. (Cladosporium spp.), Coll. spp. (Colletotrichum spp.), Cu. lun. (Curvularia lunata), Epi. pur. (Epicoccum purpurascens), F. inc. (Fusarium incarnatum), Fus. spp. (Fusarium spp.), F. ver. (F. verticillioides), Muc. spp. (Mucor spp.), Nig. spp. (Nigrospora spp.), Pen. spp. (Penicillium spp.), Phom. sp. (Phoma sp.), R. so. (Rhizoctonia solani), R. sto. (Rhizopus stolonifer), St. spp. (Stemphylium spp.), Trichod. spp. (Trichoderma spp.), and Ulo. spp. (Ulocladium spp.). The final row labeled “Egypt” in the table represents the mean frequency (%) of each fungal species across all surveyed governorates, providing an overall profile of seed-borne fungal prevalence. This summary row was excluded from comparative analyses and visualization.
The Frequency (%) and Relative abundance (%) of endophytic fungi found in maize seeds across Egypt’s 18 governorates that grow maize. Values were calculated from data aggregated from all governorates. The blue bars show number of relative abundance (%), and the orange bars show the total frequency (%). Ab. spp. (Absidia spp.), (A) alt. (Alternaria alternata), Arth. spp. (Arthrobotrys spp.), Asp. cla. (Aspergillus clavatus), Asp. fla. (A. flavus), Asp. fum. (A. fumigatus), Asp. gla. (A. glaucus), Asp. nig. (A. niger), Asp. och. (A. ochraceus), Asp. tam. (A. tamarii), Asp. terr. (A. terreus), Auro. pul. (Aureobasidium pullulans), (B) haw. (Bipolaris hawaiiensis), B. may. (B. maydis), B. tet. (B. tetramera), Bot. cin. (Botrytis cinerea), Ceph. acr. (Cephalosporium acremonium), Chaet. spp. (Chaetomium spp.), Cl. spp. (Cladosporium spp.), Coll. spp. (Colletotrichum spp.), Cu. lun. (Curvularia lunata), Epi. pur. (Epicoccum purpurascens), F. inc. (Fusarium incarnatum), Fus. spp. (Fusarium spp.), F. ver. (F. verticillioides), Muc. spp. (Mucor spp.), Nig. spp. (Nigrospora spp.), Pen. spp. (Penicillium spp.), Phom. sp. (Phoma sp.), R. so. (Rhizoctonia solani), R. sto. (Rhizopus stolonifer), St. spp. (Stemphylium spp.), Trichod. spp. (Trichoderma spp.), and Ulo. spp. (Ulocladium spp.). Values were calculated from aggregated counts of colonies and the number of sites where each species was detected across Egypt.
Species richness and Shannon–Wiener diversity index (H) of seed-borne endophytic fungi across Egypt’s 18 maize-growing governorates. The blue bars show the mean number of fungal species (species richness), and the orange bars show the mean Shannon–Wiener index (H), with error bars indicating the standard deviation across sampling sites within each governorate.
Correlations between meteorological factors and the presence of maize endophytic microbiomes
The correlation matrix among meteorological parameters revealed strong interrelationships between key climatic factors (Table 1). A significant negative correlation was observed between temperature and relative humidity (r = − 0.81), indicating that increases in temperature were generally associated with decreases in humidity. Temperature was also positively correlated with solar radiation (r = + 0.60), suggesting that warmer conditions coincided with higher levels of sunlight exposure. Other notable correlations included a modest positive association between temperature and wind speed (r = + 0.18) and a negative correlation between relative humidity and solar radiation (r = − 0.70). These interdependencies highlight the need to interpret the influence of climatic factors on fungal communities in an integrated manner.
Canonical correspondence analysis (CCA) was conducted to investigate how these climatic variables structured the composition of seed-borne fungi in maize samples across the 18 governorates. The eigenvalues indicated that the first constrained axis explained 36.6% of the total constrained inertia, while the second axis accounted for 27.0%. Together, these axes explained approximately 63.6% of the constrained variation in fungal community structure (Table 2). This proportion underscores the substantial role of climatic conditions in shaping the observed patterns.
The environmental vector fitting (envfit) analysis further quantified the relative contribution of each climatic variable to the ordination space (Fig. 7). Solar radiation exhibited the strongest loading on the second axis (CCA2 = + 0.54), while temperature contributed markedly to both axes (CCA1 = + 0.37; CCA2 = + 0.41). Relative humidity showed a prominent negative association with CCA1 (–0.47), reflecting its contrasting gradient with temperature and solar radiation. Precipitation and wind speed had comparatively smaller vector scores, suggesting more limited effects on the overall fungal assemblages.
The CCA biplot illustrated clear associations between specific fungal taxa and climatic gradients (Fig. 7). Aspergillus ochraceus, Trichoderma spp., and A. flavus clustered along the positive ends of temperature and solar radiation vectors, indicating their preference for warm, high-light environments. Conversely, Fusarium spp. and Stachybotrys spp. were positioned closer to the relative humidity vector, suggesting a greater reliance on moist conditions.
Species such as Penicillium spp. and Alternaria alternata showed intermediate positions, reflecting moderate associations with multiple climatic variables. A subset of fungi, including Epicoccum spp. and Botrytis cinerea, displayed proximity to the wind speed vector, implying potential sensitivity to air movement in dispersal or colonization. In contrast, A. glaucus exhibited a lower-than-average requirement for relative humidity but was positively associated with temperature and solar radiation. Overall, while some species demonstrated clear ecological preferences aligned with specific climatic gradients, the biplot did not reveal distinct clustering of sampling sites, indicating that the distribution of fungal taxa was relatively continuous across environmental conditions.
Canonical correspondence analysis (CCA) ordination plot showing the relationship between fungal community composition and selected climate variables across the surveyed governorates. Fungal genera are color-coded: Aspergillus (red), Fusarium (blue), Penicillium (green), Trichoderma (purple), and other genera (black). Arrows represent climate variables, each assigned a distinct color: preceptation (forestgreen), relative humidity (turquoise), solar radiation (orange), temperature (slateblue), and wind speed (deeppink). The first two canonical axes (CCA1 and CCA2) explained 36.63% and 27.0% of the constrained variance, respectively. (A) alt. (Alternaria alternata), Asp. cla. (Aspergillus clavatus), Asp. fla. (A. flavus), Asp. fum. (A. fumigatus), Asp. gla. (A. glaucus), Asp. nig. (A. niger), Asp. och. (A. ochraceus), Asp. terr. (A. terreus), Auro. pul. (Aureobasidium pullulans), (B) may. (B. maydis), Bot. cin. (Botrytis cinerea), Ceph. acr. (Cephalosporium acremonium), Chaet. spp. (Chaetomium spp.), Cl. spp. (Cladosporium spp.), Epi. pur. (Epicoccum purpurascens), F. inc. (Fusarium incarnatum), Fus. spp. (Fusarium spp.), F. ver. (F. verticillioides), Muc. spp. (Mucor spp.), Nig. spp. (Nigrospora spp.), Pen. spp. (Penicillium spp.), R. sto. (Rhizopus stolonifer), St. spp. (Stemphylium spp.), and Trichod. spp. (Trichoderma spp.).
Morpho-cultural characterization of endophytic Trichoderma isolates
All fifty Trichoderma isolates exhibited rapid growth on PDA, producing colonies typical of the genus, characterized by compact white mycelia that gradually turned green upon conidial formation. Among them, nine representative isolates (T5, T6, T11, T14, T16, T29, T30, T34, and T82) displayed distinct colony morphologies that allowed phenotypic grouping (Fig. 8).
Based on macroscopic and microscopic features, the isolates were classified into three morphological groups (Table 3). Group I (T14, T30, T34, T82) produced cottony colonies with light-green pigmentation and white centers, where conidia were evenly distributed and slightly yellowish near the center. Group II (T5, T6, T11) developed fluffy colonies with dark-green centers showing 1–2 concentric rings of dense conidial growth. Group III (T16, T29) formed velvety colonies with light olive to grey-green pigmentation, characterized by smooth margins and conidia concentrated near the colony centre.
These morpho-cultural traits clearly differentiated the isolates into consistent morphotypes and provided a basis for selecting representative strains for antagonism assays against F. verticillioides.
Dual culture assay
A dual culture assay was conducted to evaluate the antagonistic potential of 50 Trichoderma isolates against F. verticillioides. Among these, isolates T14, T30, T34, T16, and T5 demonstrated the most pronounced inhibitory effects, reducing pathogen growth by 74.03%, 73.48%, 71.67%, 71.11%, and 70.16%, respectively, after six days of incubation, most isolates showed reaction type 1 (Table S4). Notably, isolate T14 not only achieved the highest growth reduction but also produced a clear inhibition zone surrounding its colony, indicating strong antifungal activity against F. verticillioides (Fig. 9).
Representative colony morphology of selected Trichoderma isolates (T5, T6, T11, T14, T16, T29, T30, T34, and T82) grown on potato dextrose agar (PDA) after 6 days of incubation at 28 °C. All isolates exhibited rapid growth and mycelial development characteristic of the genus.
Antagonistic ability of Trichoderma endophytic isolate (T14) against Fusarium verticillioides, 8th days after inoculation, showing: the growth of F. verticillioides mycelium in the control plate (A), the growth of Trichoderma isolate T14 (B), as well as the dual culture of F. verticillioides and Trichoderma isolate (T14), demonstrating the inhibition and restriction of pathogen growth (C).
Morphological and microscopic features of T. longibrachiatum (T14)
The colony of isolate T14 exhibited rapid growth on PDA, forming abundant white aerial mycelium and prominent green conidial pustules. The colony reverse displayed a light yellowish-green pigmentation, typical of Trichoderma spp.
Scanning electron microscopy (SEM) revealed branched conidiophores terminating in phialides that bore smooth, ellipsoidal conidia. Quantitative measurements of thirty conidia showed an average length of 2.35 ± 0.69 μm (range: 0.92–3.62 μm), fitting a normal size distribution pattern (Fig. 10). These morphological characteristics are consistent with those of the T. longibrachiatum clade. The preliminary identification was verified by the Mycological Centre, Assiut University (AUMC), Egypt.
Molecular identification
BLAST analysis of the partial translation elongation factor 1-alpha (TEF1-α) sequence from isolate T14 revealed 100% identity with several T. longibrachiatum accessions (e.g., MT881871.1, MN195113.1, KF267252.1) (Table S5). The Maximum Likelihood phylogenetic tree (Fig. 11) clearly placed T14 within a well-supported T. longibrachiatum clade, confirming its taxonomic position. High bootstrap values further supported the robustness of this classification. The sequence was deposited in GenBank under accession number PP768163.1.
Colony and microscopic features of T. longibrachiatum isolate T14. (A) Colony on PDA after 7 days of incubation at 25 ± 2 °C showing white aerial mycelium with dense green conidial pustules. (B) SEM micrograph (×2000) showing branched conidiophores bearing abundant ellipsoidal conidia. (C) SEM micrograph (×5000) showing detailed conidial morphology with smooth wall structure. (D) Frequency distribution of conidial lengths (µm) following a normal curve (n = 30) generated using Origin Pro (mean = 2.35 μm; SD = 0.6.
Phylogenetic relationships of Trichoderma isolate T14 based on TEF1-α sequences. The tree was inferred using the Maximum Likelihood method and Kimura’s 2-parameter model. Bootstrap percentages (1,000 replicates) above 50% are indicated next to the branches. The analysis involved 14 sequences and was performed in MEGA 12. The isolate clustered within the T. longibrachiatum clade with high bootstrap support.
Scanning electron microscopy (SEM)
SEM observations provided direct evidence of the mycoparasitic activity of T. longibrachiatum T14 against F. verticillioides. The interaction zones revealed multiple specialized structures associated with parasitism, including hook-shaped hyphae, pincer-like projections that appeared to grip the pathogen’s hyphae, and extensive hyphal coilings enveloping the host structures. In addition, abundant conidiogenous cells and densely packed conidia were observed developing along and over the pathogen’s hyphae, suggesting progressive colonization and overgrowth. These features collectively illustrate the complex mechanisms employed by T. longibrachiatum during antagonistic interaction (Fig. 12).
A SEM micrograph demonstrating the parasitic activity of T. longibrachiatum (T14) against F. verticillioides (F.V.). (1) Normal growth of F.V. conidiophores and conidia as control. (2) A magnified F.V. conidiophores and compacted conidia (arrows). (3) Normal growth of T14 conidiophores and conidia (arrow). (4,5&6) Mycoparasitism process as parallel growth and coiling formation of T14 hyphae (arrow) over the hyphae (arrowhead) of F.V. Scale bar = 10 μm.
Discussion
This study presents a comprehensive survey of seed-borne endophytic fungi associated with maize grains cultivated across Egypt. A total of 34 fungal species from 23 genera were identified, reflecting a rich and complex mycobiome. Compared to similar studies on legumes such as peanut42, common bean and cowpea43, or even citrus fruits like Gannan navel orange44, maize appears to support a broader endophytic diversity. These comparisons underscore maize’s capacity to harbor diverse fungal endophytes—possibly due to its grain structure, cultivation scale, or environmental adaptability.
Across Egypt’s 18 maize-growing governorates, five fungal taxa A. flavus, A. niger, Penicillium spp., F. verticillioides, and Nigrospora spp. emerged as a consistent “core” endophyte group, present in nearly every seed sample. A number of additional genera—including Cladosporium, Alternaria, Aureobasidium, Trichoderma, Bipolaris, Cephalosporium, and Chaetomium—were also detected, though less uniformly. This pattern of dominance by Aspergillus, Penicillium, and Fusarium species has also been reported in maize grain studies from similar agro-climatic regions. Recent surveys in arid and Mediterranean zones of North Africa and the Middle East, including Saudi Arabia, Tunisia, and Iraq, identified F. verticillioides, A. niger, and Penicillium spp. as core components of maize and cereal seed mycobiota45,46,47. In particular, F. verticillioides consistently dominates semi-arid environments due to its tolerance to temperature and moisture fluctuations.
This dominance of Aspergillus and Penicillium is consistent with previous surveys of maize grains from warm, semi-arid regions, where these fungi thrive due to their resilience to dry conditions and potential for mycotoxin production48,49. Similarly, recent studies in Tunisia, Sudan, and Algeria have reported comparable fungal diversity ranges and dominant genera in maize and sorghum seeds, with species richness and Shannon indices reflecting the influence of arid agro-ecologies50,51. Additionally, high-throughput sequencing approaches have expanded the known diversity of maize seed mycobiomes, revealing Ascomycota-dominated communities and cryptic taxa alongside culturable genera52,53. These findings reinforce the need for integrating culture-based and molecular surveys for a complete ecological understanding.
A recent Tunisian study—conducted under a Mediterranean climate similar to Egypt’s—reported a similar pattern, with Aspergillus and Fusarium species dominating maize seeds, supporting the existence of a climate-adapted endophyte54. Recent Egyptian study reported the biodiversity assessment in maize seeds and revealed that Ustilago maydis, Alternaria alternata, Aspergillus flavus, A. niger, Penicillium spp., Cladosporium spp., and Fusarium verticillioides were the most prevalent fungi, each detected in over 90% of samples55.
However, the composition of these endophytic communities varied across regions. To explore this spatial variation, we applied the Shannon–Wiener diversity index, which integrates both species richness and evenness, to assess fungal diversity in maize seeds from each governorate56,57,58,59. The results showed that governorates such as Al-Behera, Luxor, and Al-Menia harbored the most diverse fungal communities, while Damietta exhibited the lowest diversity. These results are fully consistent with a recent study on maize seeds, which reported that Al-Menia Governorate had the most diverse and abundant fungal communities55. These differences likely reflect regional variation in microclimate, soil type, and agronomic practices. Similar patterns have been observed in in maize55 and other plant species57,58,59, where location, season, and cultivation methods significantly influence the structure of endophytic microbiomes.
The results of the CCA ordination and Pearson correlation analyses revealed distinct associations between specific fungal taxa and climatic variables such as temperature, solar radiation, and relative humidity. However, it is important to emphasize that these relationships are correlative rather than indicative of direct causality. While climatic factors likely play a significant role in shaping fungal community composition, the observed patterns may also be influenced by other environmental and biological factors not accounted for in this study.
Notably, potential confounding factors such as maize cultivar differences, agronomic practices (e.g., seed treatment, irrigation, and fertilization regimes), and soil physicochemical properties could independently or interactively affect the distribution and abundance of seed-borne endophytes. These variables were not controlled for in the present study and may partially explain regional differences in fungal community structure. Future investigations employing multivariate or controlled experimental designs are recommended to disentangle the relative contributions of these factors alongside climatic influences.
CCA revealed that the first two axes explained 36% of the variation, indicating a significant but partial climatic contribution. Trichoderma spp. and A. ochraceus were associated with higher temperature and solar radiation, while Fusarium spp. was linked to more humid conditions. Notably, a strong negative correlation between temperature and relative humidity was observed. These findings are broadly consistent with recent Egyptian research, which reported that Aspergillus species are associated with higher temperatures and solar radiation and negatively related to humidity, while Fusarium and Penicillium showed opposite patterns, and also confirmed the same inverse relationship between temperature and relative humidity using similar CCA approaches55. Comparable climate-associated patterns have also been described by Nooh et al.60 in stored grains in Egypt, where Aspergillus species increased under high temperature and low humidity, while Fusarium favoured cooler, humid conditions. Moreover, Brazilian study highlighted that environmental differences play a crucial role in shaping endophytic fungal communities in sorghum, as plants growing in humid regions supported a more diverse and abundant fungal assemblage compared with those from drier environments61. Recent studies also emphasize that interactions among temperature, relative humidity, and rainfall are key ecological drivers structuring cereal seed fungal communities in semi-arid systems45,62,63. These observations are further supported by previous reports highlighting temperature and humidity as key drivers of fungal distribution64,65,66. Presenting the correlations among meteorological parameters is essential for understanding the interrelationships between these variables. This approach has been widely adopted to illustrate how climatic factors can simultaneously influence fungal growth and dispersal67,68. For example, a strong inverse correlation between temperature and relative humidity implies that observed associations with one factor may be partly explained by the other. These findings are further corroborated by studies highlighting that A. flavus favours higher temperatures, whereas F. verticillioides thrives under more humid conditions69. This interpretation aligns closely with recent studies demonstrating that rainfall, temperature, and humidity interactively drive the assembly and diversity of maize seed-borne fungal communities55,70. These findings underscore the importance of presenting the intercorrelations among meteorological variables, as they provide essential context for understanding how multiple climatic factors can simultaneously shape fungal composition and prevalence, consistent with the present observation that Aspergillus species were linked to higher temperature and Fusarium species to more humid conditions. Overall, the results provide strong evidence that maize seeds host a consistent set of endophytic fungi across diverse agroecological zones, with potential significance for agriculture in Egypt’s semi-arid environments.
Although the remaining variation may involve other factors, such as storage practices or maize cultivar, the present results emphasize the importance of climatic conditions, which may contribute to shaping fungal assemblages. This is particularly relevant under projected climate change scenarios71.
Trichoderma isolates obtained in this study parasitized F. verticillioides in dual culture, and isolate T14 was the most aggressive, cutting pathogen growth by 74%. Similar levels of antagonism have been reported for other Trichoderma strains72, and several species (T. atroviride, T. hamatum, T. harzianum, T. longibrachiatum and T. viride) have suppressed F. oxysporum in vitro and in planta73,74,75,76.
Antagonistic activity in T. longibrachiatum is primarily mediated through the triggering of secondary metabolite pathways, which elicit defense responses against pathogens such as Fusarium oxysporum77. Furthermore, this species, along with its microbial volatile organic compounds (mVOCs), are widely recognized for their roles in plant growth promotion and biocontrol, contributing to sustainable crop production systems78. In the present study, most Trichoderma isolates showed strong antagonistic activity against F. verticillioides. These findings are consistent with recent reports demonstrating that microencapsulated formulations of T. longibrachiatum retain their antagonistic efficacy against F. oxysporum under variable environmental conditions79.
BLASTN analysis of this study placed T14 within the T. longibrachiatum clade with 100% identity to reference strains, indicating very low intraspecific divergence80,81.
In this context, the TEF1-α gene was selected as the primary molecular marker due its superior taxonomic resolution compared with ITS region82. We acknowledge that formal taxonomic frameworks for description of new species typically require a multi-locus approach, incorporating markers such as ITS, TEF1-α, and rpb2. However, within the Longibrachiatum clade, single-locus phylogenies have been shown to be highly congruent and reliable83. Accordingly, and given the limitations in sample resources in the present study, we adopted an approach consistent with recent applied investigations84, in which species identification based on high-quality TEF1-α sequencing, supported by morphological characterization, was considered scientifically robust and adequate for achieving the biocontrol objectives of this study.
Scanning-electron microscopy corroborated its mycoparasitic strategy: hyphal coils and wrapping structures enveloped F. verticillioides hyphae—features consistent with the established mechanisms of Trichoderma species, which define their ability to coil around pathogens and produce appressoria-like structures85. The coiling around the pathogens, conidial attachment, and other mechanisms of T. longibrachiatum revealed the mycoparasitic effect on Fusarium oxysporum, Fusarium solani and Fusarium pseudograminearum growth86,87. Based on the present findings, T. longibrachiatum, a seed-borne endophyte isolated from maize across diverse agroecological zones in Egypt, shows strong in vitro potential as a biocontrol agent against F. verticillioides.
Conclusion
This study provides a comprehensive assessment of seed-borne fungal endophytes associated with Egyptian maize across diverse agroecological zones. Thirty-four species were identified, with F. verticillioides, A. flavus, and Penicillium spp. forming a consistent core community across most regions. Canonical ordination analysis revealed that temperature, solar radiation, and relative humidity were the main climatic factors shaping endophytic community structure, underscoring the ecological responsiveness of maize-associated mycobiota. Among the isolates, T. longibrachiatum exhibited the strongest antagonistic activity, reducing F. verticillioides growth by nearly 74%, highlighting its potential as a promising native biocontrol candidate for maize cultivation in semi-arid regions.
Limitations
Despite these valuable insights, the study has certain limitations. Sampling was conducted during a single growing season and from a limited number of sites, which may not fully capture temporal and spatial variability in fungal communities. The identification was primarily based on culture-dependent methods, potentially excluding unculturable or cryptic taxa, and molecular confirmation was limited to T. longibrachiatum. Moreover, non-climatic variables such as soil properties, maize cultivar differences, and agronomic practices were not directly evaluated, though they likely influence the observed distribution patterns. Finally, the relationships identified between community composition and climatic factors are correlative rather than causal and should therefore be interpreted with caution.
Future directions
Future research should integrate culture-independent sequencing approaches (e.g., ITS, TEF1-α, and metagenomics) with multi-seasonal and multi-location sampling to achieve higher taxonomic resolution and ecological accuracy. Field validation of T. longibrachiatum T14, including formulation optimization and seed-coating trials, will be essential to validate its efficacy and develop endophyte-based biocontrol strategies tailored to Egyptian agroclimatic conditions.
Methods
Area of study
In 2021, a survey was carried out in Egypt’s governorates that grow maize from April to August and the geographical coordinates of all sampling locations were recorded using a global positioning system (GPS), and a map of sampling 18 governorate sites (4 villages for each) was created ArcGIS software (version 10.1; Environmental Systems Research Institute (ESRI), 2012; Redlands, CA, USA; https://www.esri.com/en-us/arcgis/products/arcgis-desktop/overview) (Fig. 13). The area of study spans latitudes between 22°33′ N and 33°975′ N, and longitudes between 27°96′ E and 33°83′ E., encompassing diverse agroecological zones ranging from arid desert regions to Mediterranean coastal areas.
Map showing the locations of maize grain sampling sites across 18 maize-producing governorates in Egypt. Each red dot represents one of the sampling sites, with four villages sampled per governorate.
Weather-related conditions
Egypt is predominantly influenced by a desert climate, ranging from semi-arid to dry. Egypt’s climate can be classified into four distinct zones: the arid desert in the south, the semi-desertic in the middle, the Mediterranean climate along the northern shore, and the red sea climate zone on the eastern coast. Upper Egypt experiences a tropical climate. The northern coastal area experiences a constant north-westerly wind from the Mediterranean Sea, which leads to moderate temperatures all year round. In contrast, the central and southern regions experience different conditions, particularly with higher nighttime temperatures during the summer. A powerful, hot, dusty, and dry wind known as Khamasīn, that originates from the south or southwest affects the country every year from March to May, causing temporary spikes in temperatures and a sharp drop in humidity below 5%. Along the Mediterranean coast, Egypt receives an average annual precipitation of 20 to 200 mm, while the central and southern regions, including Cairo, experience an average of approximately 0 mm. The country enjoys substantial annual sunshine, ranging from 3300 h in the north to 4000 h in the interior. During the maize growing season from April to August 2021, the average temperature ranged from 25.5 to 32.9 ◦C, the relative humidity was between 18.8 and 75.2%, the solar radiation levels ranged between 0.67 and 0.73 W/m², the wind speed varied between 4.25 and 5.18 m s− 1, and the rainfall measured between 0 and 0.16 mm day− 188.
Method of sampling
Samples of maize grains were collected from eight sites within each governorate. At each site, at least fifty corncobs from local white and yellow maize hybrids were randomly selected, and grains were manually separated. Samples were transported in sterile bags placed in a cold box to maintain sample integrity. Upon arrival at the laboratory, grains were spread on clean trays and left to dry at a room temperature (25 ± 2 °C) for seven days prior to processing.
Survey and isolation of endophytic fungi from maize grains
For isolation of endophytic fungi, healthy maize grains were surface sterilized by soaking in 70% ethanol for 2 min, followed by 2% sodium hypochlorite (NaOCl) for 5 min, and then 70% ethanol for 0.5 min89. The grains were washed several times with sterile water three times each for 1 min, allowed to air-dry under aseptic conditions and then the efficacy of sterilization was confirmed by imprinting the final rinse on potato dextrose agar (PDA) medium. A total of 200 grains were plated per site (10 grains per Petri dish) on PDA and incubated at 22 ± 2 °C for 7 days90. All endophytic fungi obtained were recorded and isolated in pure cultures using either the single-spore or hyphal-tip techniques. Identification of the isolates was based on morphological and cultural characteristics by experienced mycologists based on standard taxonomic keys as well as colony characteristics and microscopic features91,92,93,94. Molecular sequencing was not performed due to the large-scale nature and scope of the diversity assessment.
The following formulae were used to determine the colonization and frequency of each endophyte species:
Frequency was calculated at two levels: (i) per-governorate frequency, representing the proportion of sites within each governorate where each species occurred, and (ii) national frequency, representing the proportion of all sampling sites across all governorates where each species was detected. Frequency (%) of occurrence was defined as the proportion of sampling sites in which the species was detected:
Measures of fungal diversity
Diversity indices, including species richness and Shannon–Wiener diversity (H), were initially calculated at the site level, based on the fungal community recovered from 200 grains per site. For each governorate, the mean and standard deviation (Mean ± SD) of these eight site-level values were computed to capture within-governorate variability. Additionally, a national-level diversity index was derived by aggregating data from all 144 site-level samples across the 18 governorates.
Fungal diversity measures were taken to assess the variety of endophytic fungal species found in the maize samples gathered throughout Egypt. Using endophytes seed health testing data gathered throughout Egypt, frequency (calculated using Eq. (1) and relative abundance (evenness, %) were evaluated on a national scale. The following equation was used to estimate relative abundance:
The richness of fungal species and the Shannon–Wiener diversity index (H) was calculated for each of the 18 maize-growing governates. Species richness was determined as the total number of the fungal species identified within a governate: Species richness = total number of distinct fungus species in a maize-growing governate.
The Shannon–Wiener diversity index (H), incorporating species richness and relative abundance, was calculated using the formula:
where Pi = ni/N (ni is the number of grains with the species identified I and N is the total number of grains with all fungal species identified), representing relative abundance in fractional form. Ln refers to the natural logarithm.
Richness and Shannon diversity indices were calculated at three hierarchical scales: per site (individual sampling location), per governorate (aggregated across the eight sites within each governorate), and nationally (aggregated across all samples). Within each governorate, the mean and standard deviation (Mean ± SD) of both richness and Shannon diversity were computed from the eight site-level values to quantify within-region variability in fungal community structure.
Distribution maps were developed for the occurrence of key endophytic seed-borne fungi of maize using the software R (2020) and the packages “raster”95, “sp”96, and “ggplot2”97.
Antagonistic effect of Trichoderma spp
From the collected endophytic fungal isolates, fifty Trichoderma isolates were selected based on their high colonization frequency and distinct morphological features to maximize diversity among the recovered strains. Preliminary genus-level identification was conducted in our laboratory under the supervision of mycological experts, following the criteria described by98.
The antagonistic activity of the isolates against F. verticillioides was evaluated using the dual culture technique99. The pathogen isolate, obtained from the Agricultural Research Center, Giza, Egypt, was identified as F. verticillioides (GenBank: OM835927). For each assay, 5-mm mycelial plugs from seven-day-old cultures of both Trichoderma and F. verticillioides were placed on opposite sides of PDA plates at a 5-cm distance. Plates were incubated at 25 ± 2 °C for six days under a 12-hour photoperiod100.
Each Trichoderma isolate was tested in quadruplicate, with control plates containing only the pathogen. Representative isolates were maintained under sterile conditions for subsequent studies.
After six days of incubation, pathogen growth inhibition was calculated relative to the control using the following formula101:
where R1 is the pathogen colony radius in the control plate and R2 is the pathogen colony radius toward Trichoderma in the dual culture plate.
Between the eighth and tenth day of incubation, fungal interactions were scored on a 1–5 scale, representing levels of overgrowth and inhibition, following Bell et al.102. Colony radius was used as a practical and widely adopted metric to estimate fungal growth103. Data are presented as mean ± standard error (SE), and statistical significance was determined using ANOVA as described in the Statistical Analysis section.
Identification and morphological characterization of Trichoderma T14 isolate
The most effective Trichoderma isolate (T14), selected for its strong antagonistic activity against F. verticillioides, was cultured on PDA (DIFCO, Tucker, GA, USA) and incubated at 25 ± 2 °C for seven days. Colony characteristics, including color, texture, and growth pattern, were recorded. Preliminary morphological identification was performed according to the diagnostic criteria described by Rifai104 and Bissett105.
For taxonomic verification, the isolate was submitted to the Mycological Centre, Assiut University (AUMC), Egypt, where expert examination confirmed its identity as T. longibrachiatum Rifai (AUMC No. 16199). Quantitative analysis of conidial size was conducted using ImageJ software (version 1.54 g; NIH, USA; https://imagej.net/ij/). Thirty randomly selected conidia were measured from high-resolution SEM micrographs captured at ×2000 and ×5000 magnifications.
Descriptive statistical parameters (mean, standard deviation, range) were calculated using OriginPro 2025b (version 10.2.5.212; OriginLab Corp., USA; https://www.originlab.com/) to evaluate size variation and confirm morphological consistency.
Molecular identification and phylogenetic analysis of efficient antagonistic Trichoderma [T14]
To confirm the identity of the T14 isolate, molecular identification was conducted by targeting the translation elongation factor 1-alpha (TEF1-α) gene. This marker was specifically selected for species-level diagnosis due to its high conservation and superior phylogenetic resolution in Trichoderma compared with the ITS region, in accordance with authoritative taxonomic guidelines82 and recent applied protocols84.
Fungal isolate T14 was cultured on PDA at 25 °C for 7 days, from which total genomic DNA was extracted following the manufacturer’s protocol for the Genomic DNA Isolation (Plant) Kit (GeneDireX, cat no. NA025-0100). The TEF region of the fungus was amplified using PCR with specific primers for the TEF1-alpha gene (EF1-728 F: CATCGAGAAGTTCGAGAAGG, EF1-986R: TACTTGAAGGAACCCTTACC) on a Labnet MultiGene™ Gradient PCR thermal cycler. The PCR reaction was set up in a total volume of 25 µl, containing two microliters of DNA template, one microliter of each primer, 12.5 µl of PCR master mix, and two microliters of MgCl2 (25 mM). The PCR amplification conditions included an initial denaturation cycle at 95 °C for 5 min, followed by 35 cycles of denaturation at 95 °C for 30 s, annealing at 56 °C for 45 s, and extension at 72 °C for 40 s. The final extension was performed at 72 °C for 5 min. The amplified products were analyzed using electrophoresis on a 1.2% agarose gel. The resulting amplicons were purified and sequenced by Macrogen Inc. (Seoul, South Korea) using the Sanger method. Sequence identity was determined using the BLAST tool (https://blast.ncbi.nlm.nih.gov) to compare with GenBank entries.
Phylogenetic relationships were inferred using the Maximum Likelihood method implemented in MEGA version 12106, based on the Kimura two-parameter model of nucleotide substitution107. Sequence alignment was conducted using the MUSCLE algorithm, and branch support was assessed with 1,000 bootstrap replicates108.
It is acknowledged that molecular identification was limited to isolate T14 due to resource constraints, while the remaining isolates were identified morphologically. This is recognized as a limitation of the present study and will be addressed in future work.
The representative Trichoderma isolates used in this study are securely maintained in the Seed Pathology and Tissue Culture Laboratory, Faculty of Agriculture, Mansoura University, Egypt, where they are available upon reasonable request. We are planning to deposit these cultures in an accredited national or international culture collection facility in the near future to enhance reproducibility and access.
Ultrastructural analysis of the antagonistic interaction between Trichoderma [T14] and F. verticillioides using scanning electron microscopy
To visualize the antifungal interactions at the microstructural level, mycelial samples were collected from three zones: (1) the inhibition zone in the dual culture assay of Trichoderma T14 against F. verticillioides, (2) the actively growing edge of Trichoderma T14 (control), and (3) the actively growing edge of F. verticillioides (control). All samples were collected simultaneously from the most recent growth areas to ensure consistency in developmental stage. Sample preparation for SEM followed the method described in109. Briefly, samples were initially fixed in a solution of 2.5% glutaraldehyde and 2% paraformaldehyde in 0.1 M sodium phosphate buffer (pH 7.4) at 4 °C for 12 h. After three rinses in phosphate buffer with 0.1 M sucrose (15 min total), post-fixation was carried out using 2% osmium tetroxide for 90 min. Samples were then rinsed and dehydrated through a graded ethanol series (30–100%). After critical point drying, specimens were coated with a gold-palladium film and observed using a Jeol JSM-6510 L.V scanning electron microscope.
Statistical analyses
All statistical analyses were performed using CoStat (version 6.45; CoHort Software, Monterey, CA, USA; https://www.cohortsoftware.com/costat.html). Prior to conducting one-way analysis of variance (ANOVA), data were tested for normality using the Shapiro–Wilk test and for homogeneity of variances using Levene’s test. Only datasets meeting these assumptions were subjected to ANOVA. When significant differences were detected (p ≤ 0.05), means were compared using Tukey’s Honestly Significant Difference (HSD) test110 for multiple comparisons to identify statistically distinct groups. The significance level was set at p ≤ 0.05 for all tests.
The incidence and frequency of the recovered maize seed-borne mycoflora were assessed using Excel software to create a heatmap. Additionally, Canonical correspondence analysis (CCA) was performed using R software (version 4.5.1; https://www.r-project.org/) with the “vegan” package (version 2.7-1; https://cran.r-project.org/web/packages/vegan/index.html) to determine the effects of meteorological variables on the occurrences of fungi transmitted by maize seeds111. The analyzed meteorological variables included monthly average precipitation (mm day⁻¹), daily mean air temperature (°C), relative humidity (%), wind speed (m s⁻¹), and solar radiation (W m⁻²).
Data availability
All data generated or analyzed during this study are included within the published article and its supplementary materials. The sequencing data have been deposited in the NCBI database, with the ITS sequence under GenBank accession number PP768163.1. The fungal material used in this study was formally identified by Dr. Khalid M. Ghoneem Plant Pathologist and Dr. Yasser M. Shabana Plant Pathologist. A voucher specimen was not required for deposition in a publicly accessible herbarium for this study.
Abbreviations
- SEM:
-
Scanning electron microscopy
- GPS:
-
Global positioning system
- CCA:
-
Canonical correspondence analysis
- TEF1-α:
-
Partial translation elongation factor 1-alpha
References
Kaushal, M. et al. Maize: an underexploited golden cereal crop. Cereal Res. Commun. 51, 1–12. https://doi.org/10.1007/s42976-022-00280-3 (2022).
Wang, G. & Zhang, X. Maize in global food security: role and challenges. Field Crops Res. 7, 124–133 (2024). https://cropscipublisher.com/index.php/fc/article/html/3937
Venadan, S. et al. Variability for kernel starch components in Indian maize germplasm and identification of polymorphic molecular marker for selected waxy maize genotypes. Cereal Res. Commun. 52, 1093–1105. https://doi.org/10.1007/s42976-023-00449-4 (2023).
Food and Agriculture Organization of the United Nations (FAO). FAOSTAT statistical database & FAO. ( (2024). Available at: https://www.fao.org/faostat/en/#data/QCL (Accessed 30 Dec 2025).
Ministry of Agriculture and Land Reclamation. Summer Crops Bulletin 3, 52. Economic Affairs Sector, (2019).
Singh, H., Kaur, H., Hunjan, M. S. & Sharma, S. Unveiling toxigenic Fusarium species causing maize ear rot: insights into fumonisin production potential. Front. Plant. Sci. 16, 1516644. https://doi.org/10.3389/fpls.2025.1516644 (2025).
Cao, A., Rodríguez, A., Ramos, A. J., Sanchis, V. & Marín, S. Maize kernel metabolome involved in resistance to Fusarium ear rot and fumonisin contamination. Front. Plant. Sci. 14, 1160092. https://doi.org/10.3389/fpls.2023.1160092 (2023).
Li, Q. et al. Biocontrol and mycotoxin mitigation: an endophytic fungus from maize exhibiting dual antagonism against Fusarium verticillioides and fumonisin reduction. J. Fungi. 11, 441. https://doi.org/10.3390/jof11060441 (2025).
Wajid, K. et al. Screening of systemic fungicides against Fusarium verticilloide initiating stalk rot of maize. Agric. Biol. Res. 40, 1160–1163. https://doi.org/10.35248/0970-1907.24.40.1160-1163 (2024).
Brito, V. D., Achimón, F., Zunino, M. P. & Pizzolitto, R. P. Control of Fusarium verticillioides in maize stored in silo bags with 1-octyn-3-ol. J. Stored Prod. Res. 106, 1–7. https://doi.org/10.1016/j.jspr.2024.102279 (2024).
Pimentão, A. R., Cuco, A. P., Pascoal, C., Cássio, F. & Castro, B. B. Current trends and mismatches on fungicide use and assessment of the ecological effects in freshwater ecosystems. Environ. Pollut. 347, 123678. https://doi.org/10.1016/j.envpol.2024.123678 (2024).
Sharma, S., Kaur, T., Sharma, A. & Singh, B. (eds) Biological Control for Plant Protection: Recent Advances in Research and Sustainability (Bentham Books, 2025). https://benthambooks.com/book/9798898811204/.
Adetunji, C. O., Kumar, D., Raina, M., Arogundade, O. & Sarin, N. B. Endophytic microorganisms as biological control agents for plant pathogens: a panacea for sustainable agriculture. In Plant Biotic Interactions: State of the Art (eds (eds Varma, A., Tripathi, S. & Prasad, R.) 1–20 (Springer, https://doi.org/10.1007/978-3-030-26657-8_1 (2019).
Rezaee Danesh, Y. Endophytic fungi in agriculture: diversity, functions, and prospects for bioprotection. Int. J. Agric. Technol. 21, 2149–2168. https://doi.org/10.63369/ijat.2025.21.6.2149-2168 (2025).
Rabiae, M. et al. Leveraging endophytic fungi for enhancing plant resilience to abiotic stresses. J. Crop Health. 77, 141. https://doi.org/10.1007/s10343-025-01204-x (2025).
Ahmad, T. et al. Insights into the endophytic bacterial microbiome of Crocus sativus: functional characterization leads to potential agents that enhance plant growth, productivity, and key metabolite content. Microb. Ecol. 83, 1–20. https://doi.org/10.1007/s00248-021-01810-y (2022).
Wu, T. et al. Diversity and functional characteristics of endophytic bacteria from two grass species growing on an oil-contaminated site in the Yellow River Delta, China. Sci. Total Environ. 767, 144340. https://doi.org/10.1016/j.scitotenv.2020.144340 (2021).
Tariq, A. et al. Endophytes: key role players for sustainable agriculture: mechanisms, omics insights and future prospects. Plant. Growth Regul. 105, 1969–1990. https://doi.org/10.1007/s10725-025-01370-y (2025).
Altaf, N. et al. Endophytic colonization by Beauveria bassiana and Metarhizium anisopliae in maize plants affects the fitness of Spodoptera frugiperda (Lepidoptera: Noctuidae). Microorganisms 11, 1067. https://doi.org/10.3390/microorganisms11041067 (2023).
Fadiji, A. E. & Babalola, O. O. Elucidating mechanisms of endophytes used in plant protection and other bioactivities with multifunctional prospects. Front. Bioeng. Biotechnol. 8, 467. https://doi.org/10.3389/fbioe.2020.00467 (2020).
Andrade, G. A. K. et al. Endophytic fungi from an overlooked plant species: a case study in Kelissa brasiliensis (Baker) Ravenna. Acta Bot. Bras. 36, e2020abb0426. https://doi.org/10.1590/0102-33062020abb0426 (2022).
Mirsam, H. et al. Indigenous fungi from corn as a potential plant growth promoter and its role in Fusarium verticillioides suppression on corn. Heliyon 7, e07926. https://doi.org/10.1016/j.heliyon.2021.e07926 (2021).
Orole, O. O., Adejumo, T. O., Link, T. & Voegele, R. T. Molecular identification of endophytes from maize roots and their biocontrol potential against toxigenic fungi of Nigerian maize. Sci. Prog. 106, 368504231186514. https://doi.org/10.1177/00368504231186514 (2023).
Rojas-Sánchez, B., Castelán-Sánchez, H., Garfias-Zamora, E. Y. & Santoyo, G. Diversity of the maize root endosphere and rhizosphere microbiomes modulated by the inoculation with Pseudomonas fluorescens UM270 in a Milpa system. Plants 13, 954. https://doi.org/10.3390/plants13070954 (2024).
Yang, L. et al. The role of foliar endophytes in modulating southern corn rust severity: implications for biocontrol strategies. Front. Plant. Sci. 16, 1554915. https://doi.org/10.3389/fpls.2025.1554915 (2025).
Nikhil Reddy, K. S., Sugeetha, G. & Asha, N. N. Exploring endophytes across maize tissues: their diverse contributions to fall armyworm resistance. Biopestic Int. 20, 221–226. https://doi.org/10.59467/BI.2024.20.221 (2024).
Busby, P. E. et al. Research priorities for harnessing plant microbiomes in sustainable agriculture. PLoS Biol. 15, e2001793. https://doi.org/10.1371/journal.pbio.2001793 (2017).
Giauque, H. & Hawkes, C. V. Climate affects symbiotic fungal endophyte diversity and performance. Am. J. Bot. 100, 1435–1444. https://doi.org/10.3732/ajb.1200568 (2013).
Bokulich, N. A., Thorngate, J. H., Richardson, P. M. & Mills, D. A. Microbial biogeography of wine grapes is conditioned by cultivar, vintage, and climate. Proc. Natl. Acad. Sci. USA. 111, E139–E148. https://doi.org/10.1073/pnas.1317377110 (2014).
Shen, Y. et al. Differentiated surface fungal communities at point of harvest on apple fruits from rural and peri-urban orchards. Sci. Rep. 8, 2165. https://doi.org/10.1038/s41598-017-17436-5 (2018).
Agler, M. T. et al. Microbial hub taxa link host and abiotic factors to plant microbiome variation. PLoS Biol. 14, e1002352. https://doi.org/10.1371/journal.pbio.1002352 (2016).
Campisano, A. et al. Temperature drives the assembly of endophytic communities’ seasonal succession. Environ. Microbiol. 19, 3353–3364. https://doi.org/10.1111/1462-2920.13843 (2017).
B Zimmerman, N. & M Vitousek, P. Fungal endophyte communities reflect environmental structuring across a Hawaiian landscape. Proc. Natl. Acad. Sci. USA. 109, 13022–13027. https://doi.org/10.1073/pnas.1209872109 (2012).
Veach, A. et al. Plant hosts modify belowground microbial community response to extreme drought. mSystems 5, e00092–e00020. https://doi.org/10.1128/mSystems.00092-20 (2020).
Collado, J., Platas, G., González, I. & Peláez, F. Geographical and seasonal influences on the distribution of fungal endophytes in Quercus ilex. New. Phytol. 144, 525–532. https://doi.org/10.1046/j.1469-8137.1999.00533.x (1999).
Oita, S. et al. Climate and seasonality drive the richness and composition of tropical fungal endophytes at a landscape scale. Commun. Biol. 4, 313. https://doi.org/10.1038/s42003-021-01826-7 (2021).
Botella, L., Santamaría, O. & Diez, J. J. Fungi associated with the decline of Pinus halepensis in Spain. Fungal Divers. 40, 1–11. https://doi.org/10.1007/s13225-010-0025-5 (2010).
Gigot, C., de Vallavieille-Pope, C., Huber, L. & Saint-Jean, S. Using virtual 3-D plant architecture to assess fungal pathogen splash dispersal in heterogeneous canopies: a case study with cultivar mixtures and a non-specialized disease causal agent. Ann. Bot. 114, 863–875. https://doi.org/10.1093/aob/mcu098 (2014).
Chen, Q. L. et al. Precipitation increases the abundance of fungal plant pathogens in Eucalyptus phyllosphere. Environ. Microbiol. 23, 7688–7700. https://doi.org/10.1111/1462-2920.15728 (2021).
López-Coria, M. et al. Maize plant expresses SWEET transporters differently when interacting with Trichoderma asperellum and Fusarium verticillioides, two fungi with different lifestyles. Front. Plant. Sci. 14, 1253741. https://doi.org/10.3389/fpls.2023.1253741 (2023).
Jambhulkar, P. P. et al. Potential native Trichoderma strains against Fusarium verticillioides causing post flowering stalk rot in winter maize. Crop Prot. 152, 105838. https://doi.org/10.1016/j.cropro.2021.105838 (2022).
Huang, Y., Kuang, Z., Deng, Z., Zhang, R. & Cao, L. Endophytic bacterial and fungal communities transmitted from cotyledons and germs in peanut (Arachis hypogaea L.) sprouts. Environ. Sci. Pollut Res. 24, 16458–16464. https://doi.org/10.1007/s11356-017-9254-4 (2017).
El-Samawaty, A. E. R., Moslem, M., Sayed, S. & Yassin, M. Fungal endophytes survey of some legume seeds. J. Pure Appl. Microbiol. 8, 153–160 (2014). https://api.semanticscholar.org/CorpusID:268735179
Wang, H. et al. Isolation, identification, and antibacterial evaluation of endophytic fungi from Gannan navel orange. Front. Microbiol. 14, 1172629. https://doi.org/10.3389/fmicb.2023.1172629 (2023).
Al-Askar, A. A., Ghoneem, K. M., Hafez, E. E. & Saber, W. I. A. A case study in Saudi Arabia: biodiversity of maize seed-borne pathogenic fungi in relation to biochemical, physiological and molecular characteristics. Plants 11, 829. https://doi.org/10.3390/plants11060829 (2022).
Gargouri, S., Masiello, M., Somma, S., Mule, G. & Moretti, A. Maize–Fusarium interactions: Tunisian insights into mycotoxin ecology. Fungal Biol. 128, 2460–2470. https://doi.org/10.1016/j.funbio.2024.07.002 (2024).
Al-Masoodi, I. H., Al-Rubaye, A. F. M. & Hussein, H. J. Isolation and diagnosis of the fungi associated with maize seeds collected from local markets in Karbala, Iraq. Casp. J. Environ. Sci. 21, 665–672 (2023). https://cjes.guilan.ac.ir/article_6945.html(
Lamboni, Y. & Hell, K. Propagation of mycotoxigenic fungi in maize stores by post-harvest insects. Int. J. Trop. Insect Sci. 29, 31–39. https://doi.org/10.1017/S1742758409391511 (2009).
Goko, M. L., Murimwa, J. C., Gasura, E., Rugare, J. T. & Ngadze, E. Identification and characterisation of seed-borne fungal pathogens associated with maize (Zea mays L.). Int. J. Microbiol. 6675053. https://doi.org/10.1155/2021/6702856 (2021).
Badi, O. B. M. et al. Dominance of limited arbuscular mycorrhizal fungal generalists of Sorghum bicolor in a semi-arid region in Sudan. Soil. Sci. Plant. Nutr. 65, 570–578. https://doi.org/10.1080/00380768.2019.1680573 (2019).
Noui, A. et al. Diversity of endophytic fungal community associated with the roots of Argania spinosa (L.) Skeels growing in the arid and semi-arid regions of Algeria. Acta Agric. Slov. 114, 103–111. https://doi.org/10.14720/aas.2019.114.1.12 (2019).
Zhang, J. et al. Changes in the microflora on the seed surface and seed vigor of maize (Zea mays) under different conditions. PLoS ONE. 19, e0311258. https://doi.org/10.1371/journal.pone.0311258 (2024).
Kinge, T. R., Cason, E. D., Valverde, A., Nyaga, M. & Gryzenhout, M. Endophytic seed mycobiome of six sorghum (Sorghum bicolor) cultivars from commercial seedlots using an Illumina sequencing approach. Mycosphere 10, 1–16. https://doi.org/10.5943/mycosphere/10/1/16 (2019).
Jedidi, I. et al. Mycoflora isolation and molecular characterization of Aspergillus and Fusarium species in Tunisian cereals. Saudi J. Biol. Sci. 25, 868–874. https://doi.org/10.1016/j.sjbs.2017.11.050 (2018).
Shabana, Y. M. et al. Distribution and biodiversity of seed-borne pathogenic and toxigenic fungi of maize in Egypt and their correlations with weather variables. Plants 11, 2347. https://doi.org/10.3390/plants11182347 (2022).
Kim, B. R. et al. Deciphering diversity indices for a better understanding of microbial communities. J. Microbiol. Biotechnol. 27, 2089–2093. https://doi.org/10.4014/jmb.1709.09027 (2017).
Guevara-Araya, M. J., Escobedo, V. M., Palma-Onetto, V. & González-Teuber, M. Changes in diversity and community composition of root endophytic fungi associated with Aristolochia chilensis along an aridity gradient in the Atacama Desert. Plants 11, 1511. https://doi.org/10.3390/plants11111511 (2022).
Najjar, A. A., Alharbi, D. S., El-Zohri, M. H., Al-Hejin, A. M. & Noor, S. O. Diversity and density of endophytic fungi isolated from Calotropis procera leaves and their genotypic characterization. World Appl. Sci. J. 37, 677–689. https://doi.org/10.5829/IDOSI.WASJ.2019.677.689 (2019).
Frąc, M., Hannula, S. E., Bełka, M. & Jędryczka, M. Fungal biodiversity and their role in soil health. Front. Microbiol. 9, 707. https://doi.org/10.3389/fmicb.2018.00707 (2018).
Nooh, A., Amra, H., Youssef, M. M. & El-Banna, A. A. Mycotoxin and toxigenic fungi occurrence in Egyptian maize. Int. J. Adv. Res. 2, 521–532 (2014).
Silva, R. M. F. et al. Effect of climate and phenological stage on fungal endophytes community in Sorghum bicolor leaves. Mycol. Prog. 22, 19. https://doi.org/10.1007/s11557-023-01870-z (2023).
Abdullah, S. K. & Atroshi, H. I. M. Mycobiota associated with grains of soft wheat (Triticum aestivum L.) cultivars grown in Duhok Province, Kurdistan Region, Iraq. Int. J. Agric. Technol. 12, 91–104. https://doi.org/10.5555/20163046938 (2016). https://www.cabidigitallibrary.org/doi/pdf/
Ismail, M., El-maali, A., Omran, N. T., Nasser, M. N. & G. & Biodiversity of mycobiota in peanut seeds, corn and wheat grains with special reference to their aflatoxigenic ability. J. Microbiol. Biotechnol. Food Sci. 5, 314–319. https://doi.org/10.15414/jmbfs.2016.5.4.314-319 (2016).
Grinn-Gofroń, A., Bosiacka, B., Bednarz, A. & Wolski, T. A comparative study of hourly and daily relationships between selected meteorological parameters and airborne fungal spore composition. Aerobiologia 34, 45–54. https://doi.org/10.1007/s10453-017-9493-3 (2018).
Shinde, H. P. Influence of meteorological parameters on occurrence and composition of fungal spores in Guava Orchard at Nasik. Adv. Zool. Bot. 8, 225–232. https://doi.org/10.13189/azb.2020.080319 (2020).
Njokuocha, R. C., Agwu, C. O. C. & Okezie, C. E. A. Effects of weather conditions on selected airborne fungal spores in the southern part of the state of Enugu. Nigeria Grana. 56, 263–272. https://doi.org/10.1080/00173134.2016.1248859 (2016).
Tapia, L. et al. Rainfall and high humidity influence the seasonal dynamics of spores of Glomerellaceae and Botryosphaeriaceae genera in avocado orchards and their fruit rot association. Agronomy 15, 1453. https://doi.org/10.3390/agronomy15061453 (2025).
Grinn-Gofroń, A. & Strzelczak, A. The effects of meteorological factors on the occurrence of Ganoderma sp. spores in the air. Int. J. Biometeorol. 55, 235–241. https://doi.org/10.1007/s00484-010-0329-x (2011).
Lanubile, A., Giorni, P., Bertuzzi, T., Marocco, A. & Battilani, P. Fusarium verticillioides and Aspergillus flavus co-occurrence influences plant and fungal transcriptional profiles in maize kernels and in vitro. Toxins 13, 680. https://doi.org/10.3390/toxins13100680 (2021).
Molnár, K. et al. The effect of environmental factors on mould counts and AFB1 toxin production by Aspergillus flavus in maize. Toxins 15, 227. https://doi.org/10.3390/toxins15030227 (2023).
IPCC. Climate Change 2021: The Physical Science Basis (Cambridge University Press, 2021). https://cir.nii.ac.jp/crid/1371413280484207233.
Ma, Y., Li, Y., Yang, S., Li, Y. & Zhu, Z. Biocontrol potential of Trichoderma asperellum strain 576 against Exserohilum turcicum in Zea mays. J. Fungi. 9, 936. https://doi.org/10.3390/jof9090936 (2023).
Anjum, N. et al. Evaluations of Trichoderma isolates for biological control of Fusarium wilt of chili. Plant. Cell. Biotechnol. Mol. Biol. 21, 42–57 (2020). https://hal.science/hal-05270332
Boakye, T. A. et al. Antagonistic effect of Trichoderma longibrachiatum (TL6 and TL13) on Fusarium solani and Fusarium avenaceum causing root rot on snow pea plants. J. Fungi. 8, 1148. https://doi.org/10.3390/jof8111148 (2022).
Khan, R. A. A., Najeeb, S., Hussain, S., Xie, B. & Li, Y. Bioactive secondary metabolites from Trichoderma spp. against phytopathogenic fungi. Microorganisms 8, 817. https://doi.org/10.3390/microorganisms8060817 (2020).
Zhang, S., Xu, B., Zhang, J. & Gan, Y. Identification of the antifungal activity of Trichoderma longibrachiatum T6 and assessment of bioactive substances in controlling phytopathogens. Pestic Biochem. Physiol. 147, 59–66. https://doi.org/10.1016/j.pestbp.2018.02.006 (2018).
Abdelrahman, M., Abdel-Motaal, F. & El-Sayed, M. Dissection of Trichoderma longibrachiatum-induced defense in onion (Allium cepa L.) against Fusarium oxysporum f. sp. cepa by target metabolite profiling. Plant. Sci. 246, 128–138. https://doi.org/10.1016/j.plantsci.2016.02.008 (2016).
Sridharan, A. P., Thankappan, S., Karthikeyan, G. & Uthandi, S. Comprehensive profiling of the VOCs of Trichoderma longibrachiatum EF5 while interacting with Sclerotium rolfsii and Macrophomina phaseolina. Microbiol. Res. 236, 126436. https://doi.org/10.1016/j.micres.2020.126436 (2020).
Arias-Chavarría, L. D. et al. Evaluation of the viability of microencapsulated Trichoderma longibrachiatum conidia as a strategy to prolong the shelf life of the fungus as a biological control agent. Front. Chem. 12, 1473217. https://doi.org/10.3389/fchem.2024.1473217 (2025).
Hassan, M. M., Farid, M. A. & Gaber, A. Rapid identification of Trichoderma koningiopsis and Trichoderma longibrachiatum using sequence-characterized amplified region markers. Egypt. J. Biol. Pest Control. 29, 1–8. https://doi.org/10.1186/s41938-019-0113-0 (2019).
Liu, Z. et al. A salt-tolerant strain of Trichoderma longibrachiatum HL167 is effective in alleviating salt stress, promoting plant growth, and managing Fusarium wilt disease in cowpea. J. Fungi. 9, 304. https://doi.org/10.3390/jof9030304 (2023).
Cai, F. & Druzhinina, I. S. In honor of John Bissett: authoritative guidelines on molecular identification of Trichoderma. Fungal Divers. 107, 1–69. https://doi.org/10.1007/s13225-020-00464-4 (2021).
Druzhinina, I. S. et al. Alternative reproductive strategies of Hypocrea orientalis and genetically close but clonal Trichoderma longibrachiatum, both capable of causing invasive mycoses of humans. Microbiology 154, 3447–3459. https://doi.org/10.1099/mic.0.2008/021196-0 (2008).
Sefer, Ö., Özsoy, E., Yörük, E. & Özkale, E. Determining the biocontrol capacities of Trichoderma spp. originating from Turkey on Fusarium culmorum by transcriptional and antagonistic analyses. Front. Fungal Biol. 4, 1278525. https://doi.org/10.3389/ffunb.2023.1278525 (2023).
Sachdev, S. & Singh, R. P. Trichoderma: a multifaceted fungus for sustainable agriculture. In Ecological and Practical Applications for Sustainable Agriculture (eds (eds Bauddh, K., Kumar, S., Singh, R. & Korstad, J.) (Springer, https://doi.org/10.1007/978-981-15-3372-3_13 (2020).
Aty, A. E., Ashour, W. & A. & Applying an orthogonal array Taguchi design for chitinase optimization by Trichoderma longibrachiatum MW433820 and its efficacy in green biocontrol for sustainable agriculture. J. Microbiol. Biotechnol. Food Sci. 15, e12058. https://doi.org/10.55251/jmbfs.12058 (2025).
Boamah, S., Zhang, S., Xu, B., Zhu, N. & Li, E. Trichoderma longibrachiatum TG1 colonization and signal pathway in alleviating salinity and Fusarium pseudograminearum stress in wheat. Int. J. Mol. Sci. 26, 4018. https://doi.org/10.3390/ijms26094018 (2025).
Food and Agriculture Organization of the United Nations (FAO). Information System on Water and Agriculture, Climate Information Tool & FAO. ( (2017). Available at: https://www.fao.org/aquastat/en/ (Accessed 16 Mar 2025).
Renuka, S. & Ramanujam, B. Fungal endophytes from maize (Zea mays L.): isolation, identification and screening against maize stem borer, Chilo partellus (Swinhoe). J. Pure Appl. Microbiol. 10, 523–528 (2016).
International Seed Testing Association (ISTA). International rules for seed testing. Seed Sci. Technol. 27, 1–333 (1999).
Barnett, H. L. & Hunter, B. B. Illustrated Genera of Imperfect Fungi (APS, 1998).
Watanabe, T. Pictorial Atlas of Soil and Seed Fungi: Morphologies of Cultured Fungi and Key to Species 2nd ednCRC Press, (2002). Available at: https://doi.org/10.1201/9781420040821.
Raper, K. B. & Fennell, D. I. The Genus Aspergillus (Williams & Wilkins, 1965).
Domsch, K. H., Gams, W. & Anderson, T. H. Compendium of Soil FungiAcademic Press, Available at: https://www.cabidigitallibrary.org/doi/full/10.5555/19811962574 (1980).
Hijmans, R. J. & The R Foundation for Statistical Computing. Raster: Geographic Data Analysis and Modeling (, (2020). Available at: https://CRAN.R-project.org/package=raster
Pebesma, E. J. & Bivand, R. S. Classes and methods for spatial data in R. R News. 5, 9–13 (2005). https://cran.r-project.org/
Wickham, H. ggplot2: Elegant Graphics for Data Analysis (Springer, 2016). https://ggplot2-book.org.
Zheng, H. et al. New species of Trichoderma isolated as endophytes and saprobes from southwest China. J. Fungi. 7, 467. https://doi.org/10.3390/jof7060467 (2021).
Camporota, P. Antagonisme in vitro de Trichoderma spp. vis-à-vis de Rhizoctonia solani Kühn. Agronomie 5, 613–620. https://doi.org/10.1051/agro:19850707 (1985).
Kunova, A. et al. Selection of Streptomyces against soil-borne fungal pathogens by a standardized dual culture assay and evaluation of their effects on seed germination and plant growth. BMC Microbiol. 16, 272. https://doi.org/10.1186/s12866-016-0886-1 (2016).
Błaszczyk, L. et al. Suppressive effect of Trichoderma spp. on toxigenic Fusarium species. Pol. J. Microbiol. 66, 85–94. https://doi.org/10.5604/17331331.1234997 (2017).
Bell, D. K., Wells, H. D. & Markham, C. R. In vitro antagonism of Trichoderma species against six fungal plant pathogens. Phytopathology 72, 379–382. https://doi.org/10.1094/Phyto-72-379 (1982).
Voloshchuk, N., Irakoze, Z., Kang, S., Kellogg, J. J. & Wee, J. Three ecological models to evaluate the effectiveness of Trichoderma spp. for suppressing aflatoxigenic Aspergillus flavus and Aspergillus parasiticus. Toxins 16 (314). https://doi.org/10.3390/toxins16070314 (2024).
Rifai, M. A. A revision of the genus Trichoderma. Mycol. Pap. 116, 1–56 (1969). https://www.mycobank.org/details/19/2936
Bissett, J. A revision of the genus Trichoderma. II. Infrageneric classification. Can. J. Bot. 69, 2357–2372. https://doi.org/10.1139/b91-297 (1991).
Kumar, S. et al. Molecular evolutionary genetics analysis version 12 for adaptive and green computing. Mol. Biol. Evol. 41, 1–9. https://doi.org/10.1093/molbev/msae263 (2024).
Kimura, M. A simple method for estimating evolutionary rate of base substitutions through comparative studies of nucleotide sequences. J. Mol. Evol. 16, 111–120. https://doi.org/10.1007/BF01731581 (1980).
Felsenstein, J. Confidence limits on phylogenies: an approach using the bootstrap. Evolution 39, 783–791. https://doi.org/10.2307/2408678 (1985).
Heckman, C. A., Kanagasundaram, S., Cayer, M. L. & Paige, J. Preparation of cultured cells for scanning electron microscopy. Nat. Protoc. 2, 2760–2771. https://doi.org/10.1038/nprot.2007.504 (2007).
CoStat CoHort Software,. Version 6.45 (2008). Available at: https://www.cohortsoftware.com/costat.html.
Oksanen, J. et al. vegan: Community Ecology Package R package version 2.5-7 (R Foundation for Statistical Computing, 2020). Available at: https://cran.r-project.org/package=vegan
Acknowledgements
We extend our thanks to the Seed Pathology and Tissue Culture Laboratory at the Faculty of Agriculture, Mansoura University, where the laboratory experiments were conducted.
Funding
Open access funding provided by The Science, Technology & Innovation Funding Authority (STDF) in cooperation with The Egyptian Knowledge Bank (EKB).
Author information
Authors and Affiliations
Contributions
KMG, YMS and HMS: Conceptualization, Formal analysis, Methodology, Project administration, Resources, & software, YMS: Funding acquisition, KAH, HMS, KMG and YMS: Data curation, Investigation, Validation, Writing—original draft, & Writing—review and editing. All authors have read and agreed to the published version of the manuscript.
Corresponding authors
Ethics declarations
Competing interests
The authors declare no competing interests.
Additional information
Publisher’s note
Springer Nature remains neutral with regard to jurisdictional claims in published maps and institutional affiliations.
Supplementary Information
Below is the link to the electronic supplementary material.
Rights and permissions
Open Access This article is licensed under a Creative Commons Attribution 4.0 International License, which permits use, sharing, adaptation, distribution and reproduction in any medium or format, as long as you give appropriate credit to the original author(s) and the source, provide a link to the Creative Commons licence, and indicate if changes were made. The images or other third party material in this article are included in the article’s Creative Commons licence, unless indicated otherwise in a credit line to the material. If material is not included in the article’s Creative Commons licence and your intended use is not permitted by statutory regulation or exceeds the permitted use, you will need to obtain permission directly from the copyright holder. To view a copy of this licence, visit http://creativecommons.org/licenses/by/4.0/.
About this article
Cite this article
Hasan, K.A., Soliman, H.M., Ghoneem, K.M. et al. Diversity, climatic correlations, and biocontrol prospects of seed-borne fungal endophytes in Egyptian maize. Sci Rep 16, 10371 (2026). https://doi.org/10.1038/s41598-026-41567-3
Received:
Accepted:
Published:
Version of record:
DOI: https://doi.org/10.1038/s41598-026-41567-3